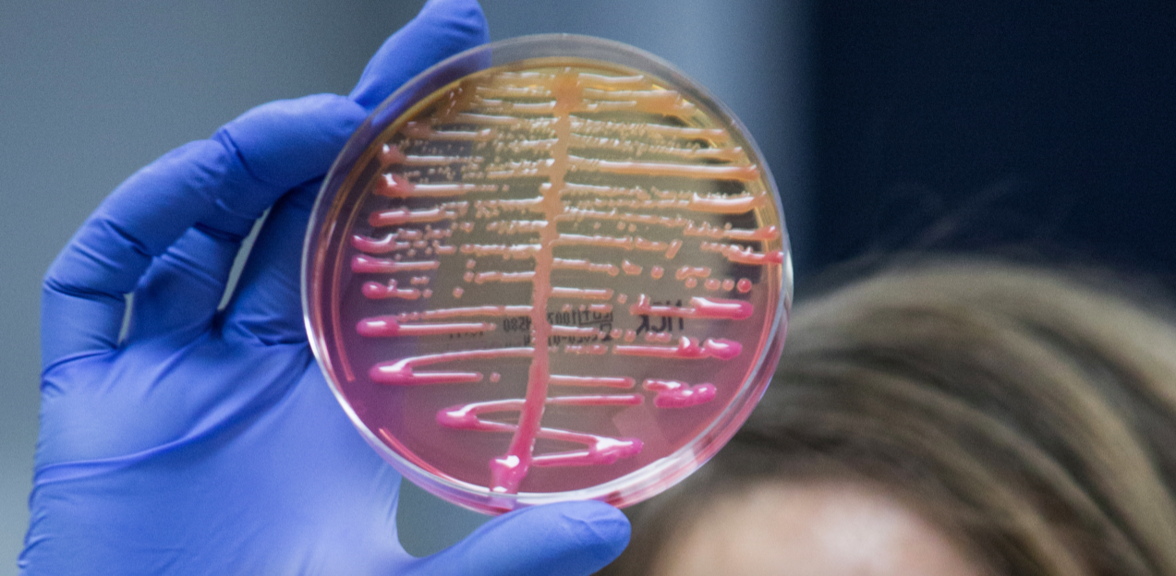
Клинико-биологическое и геномное сравнение карбапенем-резистентных Klebsiella pneumoniae с трансформацией чувствительности к полимиксину В в процессе терапии

Klebsiella pneumoniae - одна из наиболее распространенных энтеробактерий, ассоциированных с внебольничными и внутрибольничными инфекциями.
В Китае распространенность карбапенем-резистентной K. pneumoniae (CRKP), выделенной из инфекций кровотока, увеличилась до 19,6% в 2019 году. Существующий арсенал клинически доступных антибиотиков для лечения CRKP ограничен, и впоследствии инфекции CRKP характеризуются высоким уровнем смертности - 48%. Полимиксины, включая полимиксин В (PMB) и Е, стали использоваться в качестве антибиотиков последнего выбора для лечения инфекций CRKP.
По мере роста использования PMB в Китае уровень резистентности к полимиксину в клинических изолятах CRKP, по-видимому, увеличивается с 0,9% в 2014 году до 4,5% в 2019 году. Развитие резистентности к полимиксину, по-видимому, чаще происходит во время терапии полимиксином. Qureshi et al. обнаружили, что 95% (19/20) пациентов, инфицированных полимиксин-резистентными A. baumannii, до выделения получали внутривенную или ингаляционную терапию полимиксином. Влияние трансформации лекарственной чувствительности в процессе лечения полимиксином на прогноз пациентов и характеристики этиологических агентов остаются малоизученными.
В настоящем исследовании ретроспективно собраны данные пациентов, инфицированных CRKP и получавших лечение PMB. Пациенты, у которых CRKP перешел из чувствительного к PMB в резистентный к PMB, были отнесены к группе "трансформации" (TG), а пациенты с чувствительным к PMB CRKP - к группе "нетрансформации" (NTG). Целью данного исследования было:
(1) сравнение клинических характеристик и исходов у пациентов из TG и NTG,
(2) оценка факторов риска, связанных с лекарственной резистентностью во время лечения PMB,
(3) анализ геномных и вирулентно-ассоциированных фенотипических характеристик CRKP до и после трансформации чувствительности к PMB, и
(4) выяснение механизмов, лежащих в основе резистентности к PMB у клинических штаммов CRKP.
Результаты
В исследование было включено 160 пациентов (37 - в группе TG, 123 - в группе NTG). Продолжительность лечения PMB до появления резистентной к PMB K. pneumoniae (PRKP) в TG была даже больше, чем вся продолжительность лечения PMB в NTG (8 дней против 7 дней). При сравнении с изогенными PMB-чувствительными K. pneumoniae (PSKP) большинство штаммов PRKP имели миссенс-мутации в mgrB (12 изолятов), yciC (10 изолятов) и pmrB (семь изолятов). Индекс конкуренции 82,4% (28/34) пар PRKP/PSKP был меньше 1. 67,6% (23/34) и 73,5% (25/34) штаммов PRKP показали более высокую 7-дневную летальность для модельного организма Galleria mellonella и более высокую способность противостоять комплемент-зависимому киллингу, чем аналогичные им PSKP, соответственно.
Выводы
Низкие дозы и более длительные сроки лечения PMB могут быть связаны с возникновением резистентности к полимиксину. Эволюция PRKP опосредована преимущественно накоплением мутаций, в том числе в mgrB, yciC и pmrB. Наконец, PRKP продемонстрировал снижение роста и повышение вирулентности по сравнению с родительским PSKP.